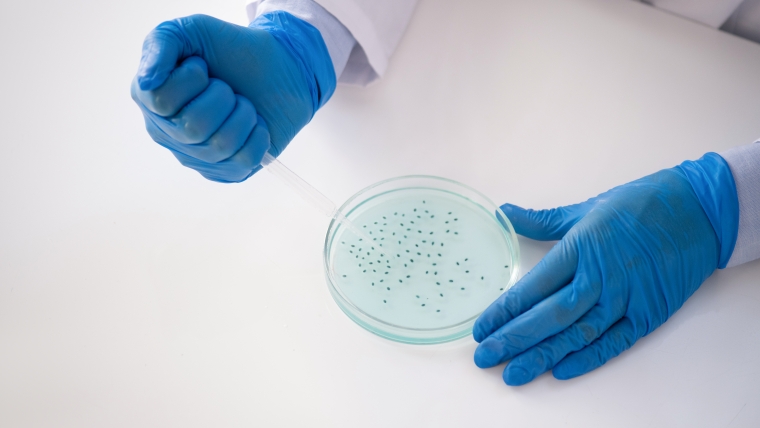

Necesitas una solucion?
Conoce nuestros servicios
En Biosoma somos profesionales, contamos con mas de 10 años al servicio dando los mejores resultados a nuestros clientes.

Estudio, diagnóstico, tratamiento y prevención de las enfermedades de la sangre y los órganos que participan en su producción.

El uso más común de los rayos X es para ver fracturas (huesos rotos), pero también se utilizan para otros usos. Por ejemplo, las radiografías de tórax pueden detectar neumonía.

Las pruebas de sangre se usan para medir o analizar células, sustancias químicas, proteínas y otros componentes de la sangre. Son uno de los tipos más comunes de pruebas de laboratorio.

se enfoca en el estudio de los microorganismos. Se dedica a su clasificación, descripción, distribución y al análisis de sus formas de vida y funcionamiento.

Se utiliza para detectar y controlar una amplia variedad de trastornos, como infecciones en las vías urinarias, enfermedad renal y diabetes.

La prueba de PSA (antígeno prostático específico) mide el nivel de PSA en la sangre.
Need a solution?
Explore My Programs
I often help in your communication by "translating." Many conflicts are due to the misunderstanding of emotional content.

Se utiliza para detectar y controlar una amplia variedad de trastornos, como infecciones en las vías urinarias, enfermedad renal y diabetes.
se enfoca en el estudio de los microorganismos. Se dedica a su clasificación, descripción, distribución y al análisis de sus formas de vida y funcionamiento.

El uso más común de los rayos X es para ver fracturas (huesos rotos), pero también se utilizan para otros usos. Por ejemplo, las radiografías de tórax pueden detectar neumonía.

Estudio, diagnóstico, tratamiento y prevención de las enfermedades de la sangre y los órganos que participan en su producción.






